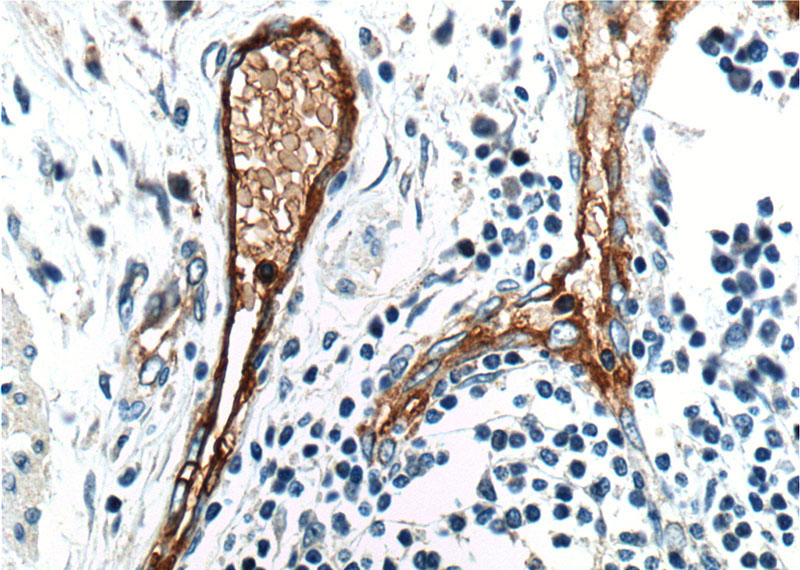
Immunohistochemistry of paraffin-embedded human colon cancer tissue slide using Catalog No:115943(ANTXR1 Antibody) at dilution of 1:200 (under 40x lens).

-
Product Name
TEM8 antibody
- Documents
-
Description
TEM8 Rabbit Polyclonal antibody. Positive WB detected in mouse testis tissue, HeLa cells, mouse lung tissue, PC-13 cells. Positive IHC detected in human colon cancer tissue. Observed molecular weight by Western-blot: 85 kDa,80 kDa
-
Tested applications
ELISA, WB, IHC
-
Species reactivity
Human,Mouse,Rat; other species not tested.
-
Alternative names
anthrax toxin receptor 1 antibody; ANTXR1 antibody; ATR antibody; FLJ10601 antibody; FLJ11298 antibody; FLJ21776 antibody; TEM8 antibody; Tumor endothelial marker 8 antibody
-
Isotype
Rabbit IgG
-
Preparation
This antibody was obtained by immunization of TEM8 recombinant protein (Accession Number: NM_018153). Purification method: Antigen affinity purified.
-
Clonality
Polyclonal
-
Formulation
PBS with 0.02% sodium azide and 50% glycerol pH 7.3.
-
Storage instructions
Store at -20℃. DO NOT ALIQUOT
-
Applications
Recommended Dilution:
WB: 1:200-1:2000
IHC: 1:20-1:200
-
Validations

mouse testis tissue were subjected to SDS PAGE followed by western blot with Catalog No:115943(ANTXR1 antibody) at dilution of 1:200

Immunohistochemistry of paraffin-embedded human colon cancer tissue slide using Catalog No:115943(ANTXR1 Antibody) at dilution of 1:200 (under 10x lens).
Immunohistochemistry of paraffin-embedded human colon cancer tissue slide using Catalog No:115943(ANTXR1 Antibody) at dilution of 1:200 (under 40x lens).
-
Background
Tumor endothelial marker 8 (TEM8, ANTXR1) and capillary morphogenesis protein 2 (CMG2, ANTXR2) are the two well-characterized anthrax toxin receptors, each containing a von Willebrand factor A (vWA) domain responsible for anthrax protective antigen (PA) binding (PMID: 23271637). TEM8 is a highly-conserved single-pass cell-surface protein overexpressed on tumor-infiltrating vasculature, and is thought to play a positive role in endothelial cell activities related to angiogenesis (PMID: 11559528; 15777794 ). The long isoforms of TEM8 have been identified as an 80-85 kDa doublet, and experimental deglycosylation reduced the molecular mass to 70 kDa, indicating that TEM8 undergoes multiple glycosylations (PMID: 14871805; 15689409).
Related Products / Services
Please note: All products are "FOR RESEARCH USE ONLY AND ARE NOT INTENDED FOR DIAGNOSTIC OR THERAPEUTIC USE"
